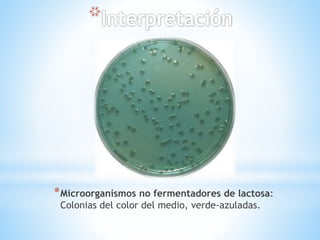
*Microorganismos no fermentadores de lactosa:
Colonias del color del medio, verde-azuladas.

Este documento describe un medio de cultivo selectivo y diferencial utilizado para el aislamiento de Salmonella spp. y Shigella spp. a partir de heces y alimentos. Contiene nutrientes, indicadores de fermentación de azúcares y sales biliares que inhiben la flora gram positiva permitiendo el crecimiento de estas bacterias. Al incubar las placas, Salmonella y Shigella crecen de distintos colores que permiten su identificación.